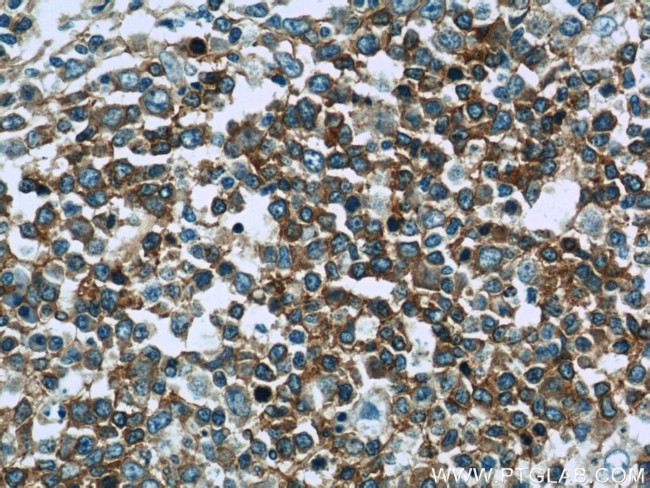
RFTN1 Antibody in Immunohistochemistry (Paraffin) (IHC (P))
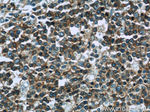
RFTN1 Antibody in Immunohistochemistry (Paraffin) (IHC (P))

Search
Proteintech
RFTN1 Polyclonal Antibody
{{$productOrderCtrl.translations['antibody.pdp.commerceCard.promotion.promotions']}}
{{$productOrderCtrl.translations['antibody.pdp.commerceCard.promotion.viewpromo']}}
{{$productOrderCtrl.translations['antibody.pdp.commerceCard.promotion.promocode']}}: {{promo.promoCode}} {{promo.promoTitle}} {{promo.promoDescription}}. {{$productOrderCtrl.translations['antibody.pdp.commerceCard.promotion.learnmore']}}
产品信息
24289-1-AP
种属反应
宿主/亚型
分类
类型
抗原
偶联物
形式
浓度
规格
纯化类型
保存液
内含物
保存条件
运输条件
产品详细信息
Immunogen sequence: ETKIDVSYE YRFLEFTTLS AAELPGSSAV RLASLRDLPA QLLELYQQGF SLAALHPFVQ PTHEREKTPL EHIFRAILIK KTDRSQKTDL HNEGYILELD CCSSLDHPTD QKLIPEFIKK IQEAASQGLK FVGVIPQYHS SVNSAGSSAP VSTANSTEDA RDAKNARGDH ASLENEKPGT GDVCSAPAGR NQSPEPSSGP RGEVPLAKQP SSPSGEGDGG ELSPQGVSKT LDGPESNPLE VHEEPLSGKM EIFTLFNKPK SHQKCRQYYP VTIPLHVSKN GQTVSGLDAN WLEHMSDHFR KGGMLVNAVF YLGIVNDSLH GLTDGVFIFE AVSTEDSKTI QGYDAIV (29-374 aa encoded by BC100667)
靶标信息
Raftlin, also known as RFTN1 (raftlin, lipid raft linker 1), cell migration-inducing gene 2 protein, PIB10, PIG9 or MIG2, is a 578 amino acid cell membrane protein and lipid anchor that is essential for raft cell assembly and maintenance. A member of the raftlin family, Raftlin modulates B-cell antigen receptor-mediated signaling, TCR signals, and is involved in T cell-mediated immune responses. The gene encoding Raftlin maps to human chromosome 3, which houses over 1,100 genes, including a chemokine receptor (CKR) gene cluster and a variety of human cancer-related gene loci. Key tumor suppressing genes on chromosome 3 include those that encode the apoptosis mediator RASSF1, the cell migration regulator HYAL1 and the angiogenesis suppressor SEMA3B. Marfan Syndrome, porphyria, von Hippel-Lindau syndrome, osteogenesis imperfecta and Charcot-Marie-Tooth Disease are a few of the numerous genetic diseases associated with chromosome 3.
仅用于科研。不用于诊断过程。未经明确授权不得转售。
生物信息学
蛋白别名: Cell migration-inducing gene 2 protein; KIAA0084; MIG2; proliferation-inducing protein 10; proliferation-inducing protein 9; Raft-linking protein; Raftlin; unnamed protein product
基因别名: KIAA0084; MIG2; PIB10; PIG9; RAFTLIN; RFTN1
UniProt ID: (Human) Q14699
Entrez Gene ID: (Human) 23180